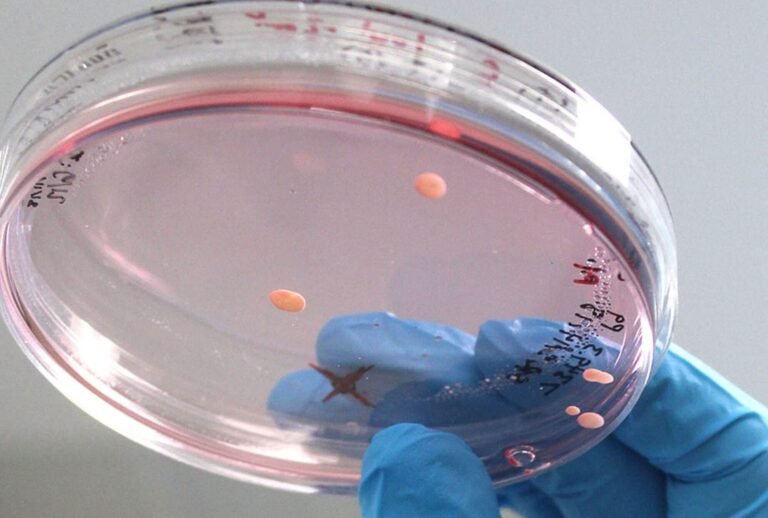
creacion-de-mini-cerebros-en-laboratorio-para-estudiar-el-autismo

Los avances tecnológicos han revolucionado el cuidado de la visión, dando paso a los lentes de contacto...
Bioingeniería
La medicina cardiovascular ha experimentado avances revolucionarios, y entre ellos destacan los . Estos dispositivos representan un...
Introducción La bioingeniería está revolucionando el campo de la robótica y la medicina con el desarrollo de...
Los avances en medicina regenerativa han dado un paso crucial con el desarrollo de . Estas innovadoras...
está transformando la medicina y la tecnología en formas antes impensables. Estos innovadores materiales, diseñados para interactuar...
La se ha posicionado como un campo prometedor en la medicina regenerativa, ofreciendo soluciones innovadoras para lesiones...
La representa un avance innovador en la investigación biomédica. Estos organoides cerebrales, desarrollados a partir de células...
marca un avance significativo en el campo de la medicina moderna. Este material, producido mediante técnicas de...
El avance de la tecnología médica ha dado un paso revolucionario con el desarrollo del páncreas artificial:...
La representa un avance revolucionario en la medicina regenerativa, ofreciendo una solución duradera para pacientes pediátricos con...